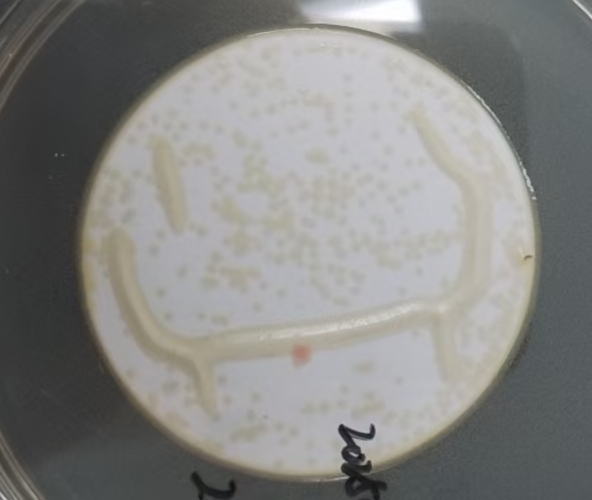
1740451056161755.png 11.png

在藥品生產與質量控制領域,藥品微生物限度檢驗是保障藥品安全性和有效性的關鍵環節。它通過對藥品中微生物污染狀態的檢測,判斷藥品是否符合質量標準要求,從而降低藥品使用過程中的不良反應和風險。然而,在實際操作中,藥品微生物限度檢驗不可避免地會產生誤差,這些誤差對藥品質量判斷和生產過程帶來諸多影響。深入剖析誤差產生的原因、影響,并采取有效的控制措施,對于提升藥品質量安全水平至關重要。
一、誤差產生的原因
樣品處理環節的漏洞
樣品處理是藥品微生物限度檢驗的首要且關鍵步驟,其誤差來源廣泛。樣品采集時,若未能嚴格遵循無菌操作原則,例如采樣人員未正確穿戴無菌防護裝備,采樣工具未經嚴格滅菌處理,就可能引入額外的微生物,導致樣品中微生物數量異常增加。同時,忽視溫度控制也會產生嚴重后果,某些對溫度敏感的微生物在不適宜的溫度下,其生長活性會發生改變,進而影響檢驗結果的準確性。此外,樣品保存和傳遞過程中,如果保存條件不當,如未在規定的低溫環境下保存,或者傳遞時間過長、運輸條件不穩定,都可能造成樣品中微生物的增殖或死亡,干擾檢驗結果。
檢測方法的選擇與操作不當
藥品微生物限度檢驗方法豐富多樣,涵蓋傳統培養方法、生化方法以及免疫學方法等。每種方法都有其獨特的檢測靈敏度、特異性、快速性和成本特點。在選擇檢測方法時,若未充分考慮藥品的特性、檢測目的以及實驗室的實際條件,就可能導致方法不適用。例如,對于一些含有特殊成分的藥品,傳統培養方法可能無法準確檢測其中的微生物,因為藥品成分可能抑制微生物的生長。此外,即使選擇了合適的方法,若操作人員在操作過程中未能嚴格按照標準流程進行,如培養基的配制比例不準確、加樣量存在偏差等,同樣會引發誤差。
操作人員技能的參差不齊
操作人員的技能水平在藥品微生物限度檢驗中起著決定性作用。這不僅要求操作人員具備扎實的實際操作能力,能夠熟練完成各種實驗操作,如樣品的稀釋、接種、培養等,還需要其掌握深厚的檢驗技能知識,包括微生物學基礎理論、藥品檢驗相關法規等。同時,豐富的實用經驗也不可或缺,經驗豐富的操作人員能夠敏銳地察覺實驗過程中的細微異常,并及時采取正確的處理措施。相反,若操作人員技能不足,缺乏對實驗細節的把控能力,就容易在各個操作環節引入誤差。

二、誤差帶來的影響
藥品質量的誤判
藥品微生物限度檢驗誤差最直接的影響就是導致藥品質量的誤判。當檢驗結果存在誤差時,可能會將實際微生物污染超標的藥品判定為合格,這將使不合格藥品流入市場,嚴重威脅患者的用藥安全,可能引發嚴重的不良反應,甚至危及生命。反之,也可能將合格藥品誤判為不合格,導致藥品生產企業的經濟損失,同時造成藥品資源的浪費。這種誤判會極大地影響藥品的有效性和安全性,干擾臨床治療效果,破壞醫患之間的信任關系。
成本的顯著增加
藥品微生物限度檢驗誤差會給藥品生產企業帶來沉重的成本負擔。一旦出現誤差,企業為了確保藥品質量,需要投入更多的人力進行重復檢驗和數據核對,安排專業人員對誤差原因進行調查分析。物力方面,需要消耗更多的實驗耗材,如培養基、試劑、采樣工具等,同時可能需要使用更先進的檢測設備進行進一步的驗證。財力上,不僅要支付額外的人力和物力成本,還可能因為藥品的誤判導致產品召回、市場信譽受損等間接經濟損失,這些都極大地增加了企業的生產成本,降低了企業的市場競爭力。
三、控制誤差的有效措施
強化操作人員培訓
對操作人員進行全面、系統的培訓是控制誤差的基礎。培訓內容應涵蓋藥品微生物限度檢驗的操作規范,詳細講解每個操作步驟的要點和注意事項,使操作人員養成良好的操作習慣。同時,加強檢測方法和技能培訓,讓操作人員深入了解各種檢測方法的原理、適用范圍和優缺點,能夠根據實際情況準確選擇合適的方法,并熟練掌握操作技巧。此外,定期組織培訓考核,確保操作人員的技能水平始終保持在較高狀態。
制定并嚴格執行標準操作規程
制定詳細的藥品微生物限度檢驗標準操作規程是規范操作的關鍵。該規程應明確操作流程,從樣品采集、處理、檢測到結果報告的每一個環節都要有清晰的規定。同時,要明確操作方法,如培養基的制備方法、微生物計數方法等,以及檢測過程的關鍵環節,如無菌操作的要求、培養條件的控制等。在實際操作中,要求操作人員嚴格按照標準操作規程進行,減少人為因素導致的誤差。
確保樣品的完整性
在樣品采集、保存和傳遞環節,要全程保持高度的無菌意識。采樣人員應嚴格按照無菌操作規范進行采樣,確保采樣工具和容器的無菌性。樣品保存時,要根據藥品的特性選擇合適的保存條件,如溫度、濕度等,并定期檢查樣品的狀態。在傳遞過程中,要采取有效的防護措施,避免樣品受到震動、碰撞、污染等,保證樣品的完整性和數量的穩定性。
科學選擇檢測方法
根據藥品的性質、微生物污染的特點以及實驗室的實際條件,科學合理地選擇檢測方法。在選擇培養基和試劑時,要確保其質量可靠,能夠滿足檢測要求。同時,不斷優化檢測方法,提高檢測方法的靈敏度和特異性,減少誤差的產生。例如,可以采用先進的自動化檢測設備,提高檢測的準確性和重復性。

藥品微生物限度檢驗誤差的控制是一個系統工程,需要從樣品處理、檢測方法選擇、操作人員技能提升等多個方面入手。只有全面深入地分析誤差產生的原因和影響,并采取切實有效的控制措施,才能提高藥品微生物限度檢驗的準確性和可靠性,為藥品質量和安全提供堅實的保障。藥品生產企業和監管部門應高度重視這一問題,共同努力提升藥品質量安全管理水平,確保公眾用藥安全有效。







客服1